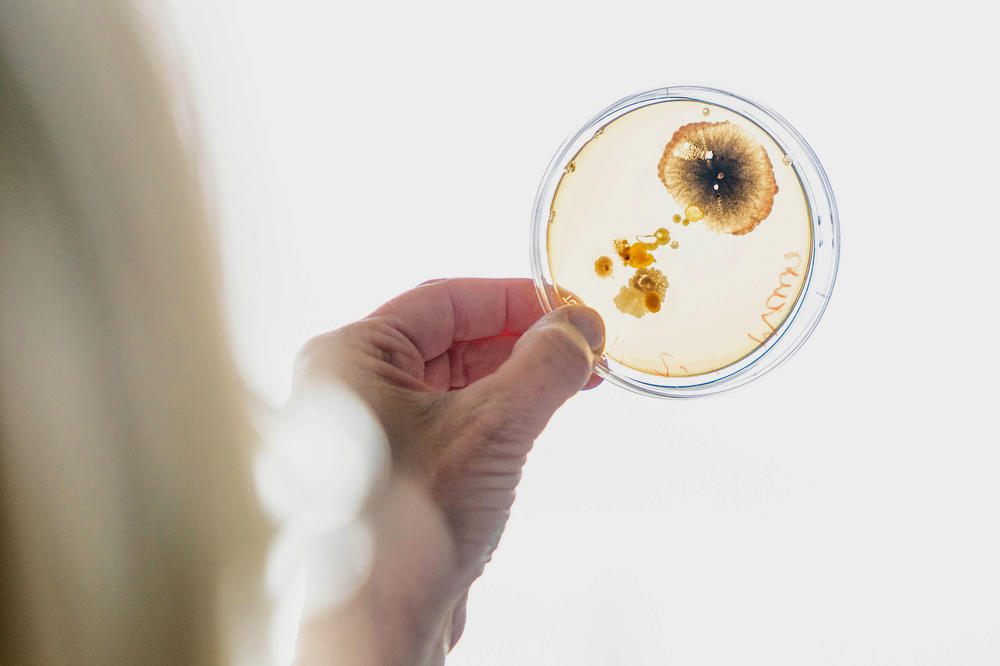
Hand einer Frau hält eine transparente Petrischale mit braunen Pilzproben hoch

Ombudspersonen für wissenschaftliche Integrität
Im Interview: Die Psychologin Steffi Pohl und der Tiermediziner Georg von Samson-Himmelstjerna setzen sich an ihren Fachbereichen für gute wissenschaftliche Praxis ein
08.04.2022
Hypothese, Experiment, Auswertung, Veröffentlichung – Forschung sollte in allen Phasen transparent, fair und ehrlich sein. Dezentrale Ombudspersonen an den Fachbereichen beraten und vermitteln im Konfliktfall.
Bildquelle: Michael Fahrig
Im vergangenen Jahr wurde das Ombudswesen für wissenschaftliche Integrität an der Freien Universität Berlin neu aufgestellt. Neben einer zentralen Ombudsperson beraten und unterstützen gewählte Ansprechpersonen an den Fachbereichen vertraulich in Fragen guter wissenschaftlicher Praxis. Steffi Pohl, Professorin für Methoden, Evaluation und Qualitätssicherung in der Erziehungswissenschaft und der Psychologie, ist seit Mitte 2021 Ombudsperson für wissenschaftliche Integrität am Fachbereich Erziehungswissenschaft und Psychologie. Georg von Samson-Himmelstjerna, Professor für Parasitologie am Fachbereich Veterinärmedizin, übt dieses Amt an seinem Fachbereich bereits seit sechs Jahren aus.
Frau Professorin Pohl, Herr Professor von Samson-Himmelstjerna, welche Aufgaben sind mit dem Amt einer Ombudsperson verbunden?
Steffi Pohl: Wir sind Ansprechpersonen für Fragen zur wissenschaftlichen Integrität für alle Universitätsangehörigen, von Studierenden über wissenschaftlich Mitarbeitende und wissenschaftsunterstützendes Personal bis zu hin zu Personen, die eine Professur innehaben. Wir sind zwar keine rechtliche Instanz und fällen keine Entscheidungen, aber wir helfen, Konflikte frühzeitig zu lösen. In meinem bisher einzigen Fall als Ombudsperson ist das gut gelungen, weil die Betroffenen sich bei mir gemeldet haben, bevor es zu einer Eskalation kommen konnte.
Gleichzeitig kümmern wir uns darum, dass am Fachbereich Workshops zu guter wissenschaftlicher Praxis angeboten werden. Und wir tauschen uns mit der zentralen Koordinierungsstelle an der Freien Universität über unsere Aktivitäten aus. Jedes Jahr findet ein großes Treffen der dezentralen Ombudspersonen statt – das letzte war gerade erst vor ein paar Wochen.
Die Erziehungswissenschaftlerin Steffi Pohl ist seit Mitte 2021 Ombudsperson für wissenschaftliche Integrität am Fachbereich Erziehungswissenschaft und Psychologie.
Bildquelle: Bernd Wannenmacher
Georg von Samson-Himmelstjerna: In diesem Rahmen bewege ich mich auch am Fachbereich Veterinärmedizin. Zusammen mit anderen Personen aus dem Fachbereich organisiere ich zum Beispiel Fortbildungen, vor allem für Promovierende. Die Teilnahme an diesen Veranstaltungen wurde in unserer Promotionsordnung festgeschrieben, sodass sie auch für Promovierende außerhalb von Promotionsprogrammen Pflicht ist. Mein Kollege Jürgen Krücken und ich haben außerdem selbst ein Teacher’s Training zu guter wissenschaftlicher Praxis absolviert.
Wo setzen Sie Ihre Schwerpunkte?
Georg von Samson-Himmelstjerna: Es ist mir ein großes Anliegen, nicht nur Promovierende, sondern alle Projektleitenden zu erreichen. Wir wollen alle, die wissenschaftliche Arbeiten betreuen, informieren und fortbilden. Dass an vielen Stellen Wissen fehlt, sehen wir auch, wenn Promovierende berichten, wie Laborbücher oder die Datensicherung in ihren Arbeitsgruppen gehandhabt werden.
Seit einem Jahr nutzen jedoch die meisten Einrichtungen am Fachbereich Veterinärmedizin das digitale Laborbuch Labfolder. Das hilft in vielerlei Hinsicht: Die Dokumentation ist fälschungssicher, die Daten können nicht zerstört werden oder verlorengehen.
Steffi Pohl: Auch bei uns werden einige Regeln und Abläufe noch nicht einheitlich umgesetzt. Dadurch entstehen Unklarheiten bei den Studierenden. Deshalb arbeite ich unter anderem mit der Leiterin des Prüfungsausschusses an einem Regelwerk für Studierende und Dozierende, das klarstellen soll, wie die Regeln lauten und was passiert, wenn man sie nicht einhält.
Studierende, die voneinander abschreiben, haben oft kein Problembewusstsein. „Das machen doch alle“ ist ein beliebtes Argument. Wir müssen aber früh vermitteln, dass ein solches Verhalten auch bei einem Praktikumsbericht nicht tolerierbar ist, sonst führt das spätestens in der Dissertation zu großen Problemen.
Deshalb sollten wir eine gemeinsame Haltung haben und klar kommunizieren, wofür wir stehen, denn es geht um die Glaubwürdigkeit der Wissenschaft. Bei Themen wie Corona oder Klimawandel sehen wir gerade, wie wichtig Vertrauen in wissenschaftliche Erkenntnisse ist.
Gibt es fachbereichsspezifische Konflikte?
Georg von Samson-Himmelstjerna: Wir sind in der guten Situation, dass in der Tiermedizin kaum krasse Fälle von wissenschaftlichem Fehlverhalten auftreten. Konflikte zur Autorenschaft gibt es ab und zu, aber viel seltener, als ich es etwa aus anderen Fachbereichen höre. Am häufigsten sehen wir Plagiate in den Einleitungskapiteln von Dissertationen, wo Material und Methoden dargestellt werden, aber kaum im experimentellen Teil, wo es um neue Ergebnisse geht.
Der Tiermediziner Georg von Samson-Himmelstjerna ist seit sechs Jahren dezentraler Beauftragter für gute wissenschaftliche Praxis am Fachbereich Veterinärmedizin.
Bildquelle: Bernd Wannenmacher
Aber ist der experimentelle Teil nicht auch gefährdet – wenn etwa Messungen leicht korrigiert werden, um Hypothesen zu bestätigen?
Georg von Samson-Himmelstjerna: Die Gefahr besteht natürlich. Wir gehen auch in Fortbildungen darauf ein. Promovierende bitten oft um Rat, etwa wenn es darum geht, Abbildungen von molekularen oder immunologischen Analysen darzustellen. Es gibt ja viele technische Möglichkeiten, solche Bilder zu bearbeiten, aber die Frage ist immer, was im Rahmen guter wissenschaftlicher Praxis erlaubt ist. Eine häufige Frage ist auch, ob man Ausreißer, also einzelne, stark abweichende Messergebnisse, aus einer Datenanalyse ausschließen darf.
Steffi Pohl: In der Psychologie nahm die sogenannte Replikationskrise ihren Anfang: Befunde aus veröffentlichten Studien ließen sich von unabhängigen Forschungsgruppen nicht wiederholen. Ein internationales Forschungsteam wiederholte 100 psychologische Studien, die in führenden Fachzeitschriften veröffentlicht worden waren, und kam 2015 zu dem Schluss, dass weniger als die Hälfte aller Replikationsversuche das Originalergebnis bestätigen.
Manche Abweichungen blieben im Rahmen von plausiblen Variationen. Andere stellten die wissenschaftliche Integrität in Frage: Sie deuteten unter anderem auf „HARKing“ hin. So wird es genannt, wenn Forschende in ihrer Studie zuerst nach positiven Ergebnissen suchen und die Forschungsfrage nachträglich anpassen. Das Problem gibt es zwar auch in anderen Disziplinen, aber in der Psychologie ist es durch die groß angelegte Studie zur Überprüfung bekannt geworden. Seither gibt es viel Bewegung und Überlegungen dazu, was man dagegen tun kann.
Und was kann man dagegen tun?
Steffi Pohl: Sehr sinnvoll finde ich zum Beispiel die Vorab-Registrierung von Studien: Bevor Forschende überhaupt Daten erheben, legen sie ihr gesamtes Forschungsvorhaben detailliert offen – einschließlich der Auswertungspläne. Manche Zeitschriften praktizieren sogar eine „acceptance in principle“. Dabei wird die Vorab-Registrierung begutachtet. Wird diese als überzeugend bewertet, werden die Ergebnisse anschließend auf jeden Fall wie geplant veröffentlicht, ganz gleich, wie sie ausfallen. Denn auch negative oder unerwartete Ergebnisse sind wertvoll für die Wissenschaft.
Die Psychologie hat aus der Replikationskrise eine Stärke gemacht und zum Beispiel die Open-Science-Bewegung gefördert, die meiner Meinung nach die Wissenschaft revolutioniert. Ähnlich sollten wir es an der Freien Universität nach dem Fall Giffey machen. Das Problem eines Plagiats ist ja nicht nur bei uns aufgetreten. Wir nutzen es aber als Gelegenheit, um das Wissenschaftssystem zu verbessern.
Georg von Samson-Himmelstjerna: Es ist gut, dass es an der Freien Universität jetzt eine hauptamtlich arbeitende Koordinierungsstelle für wissenschaftliche Integrität gibt. Diese Investition in Personal wird sich bemerkbar machen. Wir Ombudspersonen arbeiten ja ehrenamtlich, und auch alle anderen Forschenden haben sehr viele andere Aufgaben. Wenn ich eine Fortbildung für Projektleitende anbiete, dann kommen höchstens 10 bis 20 Prozent. Den anderen ist eine dreistündige Veranstaltung zu lang.
Steffi Pohl: Ich denke, das Bewusstsein für das Thema ist da. Aber Forschende müssen mit ihrer Zeit haushalten. Wenn man dem Thema mehr Gewicht geben will, sollte sich dies in den Anreizsystemen widerspiegeln, ähnlich wie für Open Science.
Georg von Samson-Himmelstjerna: Wenn wir es schaffen, von den Studierenden bis zu den Projektleitenden gute wissenschaftliche Praxis nicht nur als Thema bekanntzumachen, sondern die Prinzipien zu vermitteln und im Forschungsalltag zu verankern, dann haben wir unser Ziel erreicht.
Die Fragen stellte Marion Kuka
Weitere Informationen
- Mehr erfahren: Schwerpunktthema gute wissenschaftliche Praxis im Profil der Freien Universität
-
Übersicht der dezentralen Ombudspersonen der Fachbereiche mit Kontaktdaten
-
Satzung zur Sicherung guter wissenschaftlicher Praxis (GWP-Satzung)
-
Satzung zur Sicherung guter wissenschaftlicher Praxis (GWP-Satzung) in englischer Sprache